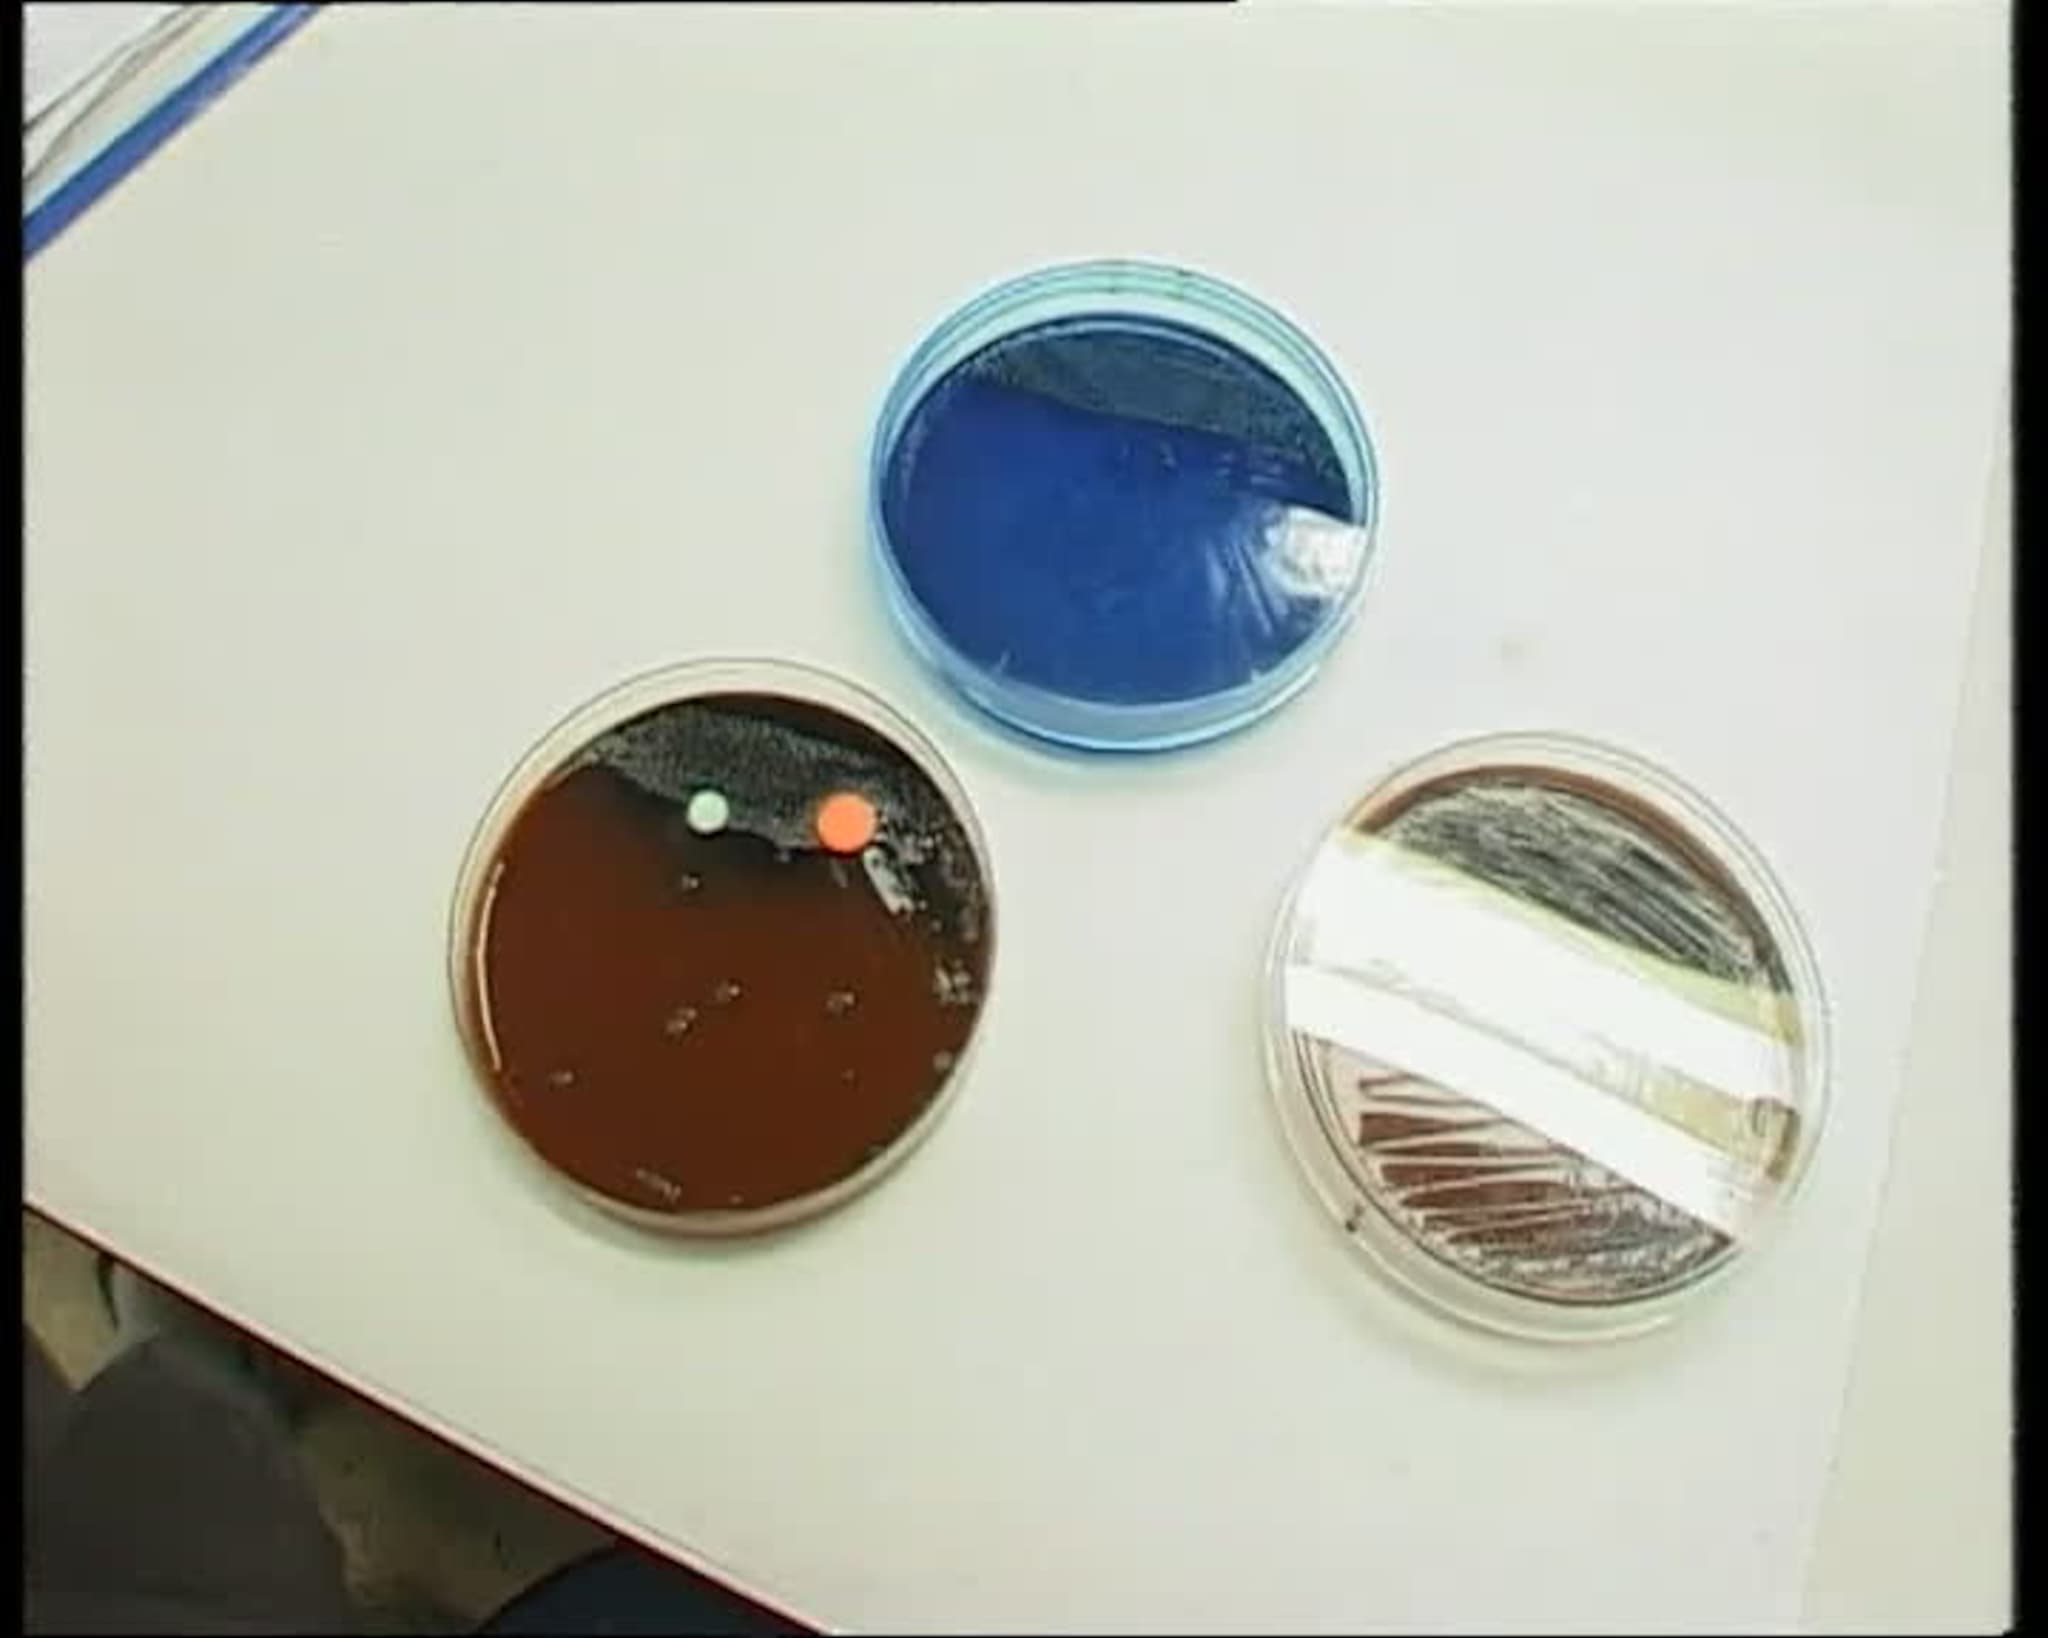
TVSør 24.03.2004

TVSør 24.03.2004
* 0.57: Tobakkstyverier * 2.35: Ninja * 3.05: Snøgg-krav * 3.35: Fyrvokter * 5.31: Trening * 7.23: Motordrevne. Tradisjonelle fysioterapeuter er skeptiske. * 7.53: Ulvejakt * 8.23: Kunstnerhus * 11.23: Gjenbrukskunst * 13.12: Ting * 13.27: Geit i Fengsel * 17.20: Været * 20.19: Mitt Sørland * Lyn vil ha Vågs Espen Børufsen Start og MK snapper opp de fleste lokale stortalentene for å utvikle dem videre. Men det forhindrer ikke Osloklubben Lyn fra å ønske seg en 16-åring fra Vågsbygd. I innslaget: Are J. Heiseldal, reporter, TVSør; Odd Arild Skonhoft, trener, IK Våg; Espen Børufsen, talent, IK Våg; Foto: Are J. Heiseldal, TVSør * Kunstnerhus Ekserserhuskvartalet i Kristiansand har den siste tiden utviklet et levende kunstmiljø i byen. Leietakere er nå på plass i alle verkstedene kommunen leier ut her, og det ble idag markert av koreografigruppa Loop Loop Loop. I innslaget: Morten Liene, kunstner; Egil Steinsland, reporter; Else Marie Jakobsen, kunstner; Andé Tribbensée, kunstner; Foto, Per Kåre Sandbakk * Nytt inbrudd i natt Tobakkstyver herjer i Mandal og i natt slo de til igjen. Denne gangen var det joker butikken i Holum som fikk besøk av ukjente gjerningsmenn. I innslaget: Pål Jørgensen, reporter; Bjart Gabrielsen, politistasjonssjef Mandal; Arild Fredriksen, butikkeier Narvesen; Foto: Pål Jørgensen * Vbkninjaran Mannen som i går ble pågrepet for å ha ranet Shellstasjonen i Arendal sentrum, ringte selv til Agderposten og tipset om saken. Tipset gikk ut på at en mann i fullt ninjautstyr stod bak det hele, og at han hadde både sverd og kniv med seg. Deretter krevde han 1000 kroner i tipshonorar for de verdifulle opplysningene. I følge redaktør Stein Gauslaa, hadde ikke avisen grunn til å tvile på at mannen snakket sant. Av Agderposten ble mannen bedt om å kontakte politiet. I innslaget: FOTO: ERIK HOLAND, AGDERPOSTEN * Geit i fengsel Politiet i Mandal fikk et uvanlig besøk i arresten i natt. Da en mann ble innbrakt for promillekjøring, måtte også hans uskyldige medpassasjerer overnatte innenfor murene. I innslaget: Christian Wulff, reporter; Bjart Gabrielsen, politistasjonssjef; Foto: Pål Jørgensen * Snart er 160 års historie historie i Arendal I over 150 år har Torungen fyr i innseilingen til Arendal vært bemannet av folk, men 1 juli er det slutt. Da automatiseres fyrtårnet, og for Fyrvokter Per Solli, nærmer siste arbeidsdag seg… I innslaget: REPORTER: MORTEN W. JØRGENSEN; PER SOLLI, FYRVOKTER; FOTO: STEIN HARALD ØIGÅRD, AGDERPOSTEN * 040324-regresskrav mot Snøgg * Ulv Ulvejegerne i Aust-Agder har funnet ferske spor etter ulven innenfor fellingsområdet. Ulven hadde satt fra seg tydelige potemerker i snøen og jaktlaget har nå økt bemanningen igjen til vel 20 jegere. Ulvejakten omorganiseres for å forsøke å ringe inn ulven. Fellingstillatelsen går ut om åtte dager. Jakten pågår i kommunene Grimstad, Arendal, Froland, Birkenes og Åmli, men jegerne vil ikke røpe hvor sporene er funnet, av frykt for aksjoner. I innslaget: Bilder fra Dyreparken * Trening, vb Ikke alle med belastningsskader på Sørlandet får nødvendig oppfølging og trening, mener personalet på Anines Trim og Trivsel i Grimstad. I mange år har det alternative treningsstudioet gitt folk med ulike plager den oppfølging de trenger. I innslaget: Ingmar Brokka Rike, TVAust-Agder; Videojournalist; Bente Sveum; Daglig leder; Laila Asbjørnsen * Spedbarnsdød Spedbarnsdødeligheten i Aust-Agder er den høyeste i landet. Det viser statistikken over barn som dør før de har fylt ett år. Fylkeslege i Aust-Agder, Anne Sofie Syvertsen, sier dette har vært en tendens gjennom hele 90-tallet og fram til i dag. Hun mener det høye antallet gravide kvinner som røyker under svangerskapet kan være en av årsakene til den høye spedbarnsdødeligheten. Også i Vest-Agder er spedbarnsdødeligheten høyere enn landsgjennomsnittet. I innslaget: ARKIVBILDER